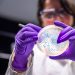
Η λίστα με τις 24 πιο μολυσματικές ασθένειες

Με μεγάλη επιτυχία και τη συμμετοχή πάνω από 70 φοιτητών των προγραμμάτων Μεταπτυχιακών Σπουδών της Ιατρικής Σχολής του ΕΚΠΑ «Ανάπτυξη νέων φαρμάκων: έρευνα, κυκλοφορία και πρόσβαση» και «Ογκολογία θώρακος: σύγχρονη κλινικοεργαστηριακή προσέγγιση και έρευνα» σε συνεργασία με τον Σύνδεσμο Φαρμακευτικών Επιχειρήσεων Ελλάδος (ΣΦΕΕ) πραγματοποιήθηκε η εκδήλωση «Ημέρα Καριέρας», την Παρασκευή 28 Μαρτίου 2025 στο Ξενοδοχείο Crowne Plaza στην Αθήνα.
Η «Ημέρας Καριέρας» προσέφερε σε περισσότερους από εβδομήντα (70) μεταπτυχιακούς φοιτητές των ως άνω προγραμμάτων τη δυνατότητα διασύνδεσης με την αγορά εργασίας, καθώς γνώρισαν και συνομίλησαν με εκπροσώπους φαρμακευτικών εταιρειών μελών του ΣΦΕΕ. Οι φοιτητές είχαν την ευκαιρία να ενημερωθούν για τις προοπτικές και τη δυναμική του φαρμακευτικού κλάδου, καθώς και για τις τάσεις και τις επαγγελματικές προοπτικές που διαγράφονται στο χώρο της Υγείας. Κατά τη διάρκεια της εκδήλωσης πραγματοποιήθηκαν πάνω από 200 συνεντεύξεις των εταιρειών με τους φοιτητές και απόφοιτους των Μεταπτυχιακών Προγραμμάτων σε προκαθορισμένα ραντεβού.

Ο Καθηγητής Παθολογίας-Ογκολογίας της Ιατρικής Σχολής του Πανεπιστημίου Αθηνών και Διευθυντής της Γ΄ Πανεπιστημιακής Παθολογικής Κλινικής και Ομώνυμου Εργαστηρίου, ΓΝΝΘΑ «Η ΣΩΤΗΡΙΑ» Διευθυντής του Μεταπτυχιακού Προγράμματος, κ. Κωνσταντίνος Συρίγος δήλωσε σχετικά: «Η Ημέρα Καριέρας αποτελεί ένα σημαντικό βήμα για τη διασύνδεση του ακαδημαϊκού χώρου με την αγορά εργασίας, προσφέροντας στις εταιρίες που δραστηριοποιούνται στο χώρο του φαρμάκου πρόσβαση σε εξειδικευμένο ανθρώπινο δυναμικό, ενώ ταυτόχρονα επιτρέπει στους υποψηφίους να ανακαλύψουν νέες επαγγελματικές προοπτικές. Οι φοιτητές και απόφοιτοι των Μεταπτυχιακών Προγραμμάτων είχαν την ευκαιρία να ανακαλύψουν τις δυνατότητες που προσφέρει ο κλάδος της φαρμακευτικής βιομηχανίας ενώ η εκδήλωση είχε στόχο να προάγει την καινοτομία και τη συνεχιζόμενη εκπαίδευση.»

Η Διευθύντρια Επικοινωνίας του ΣΦΕΕ, κα Μαρία Λεοντάρη στον χαιρετισμό της ανέφερε: «Πιστοί στο ραντεβού μας είμαστε εδώ στην «Ημέρα Καριέρας» για δεύτερη συνεχόμενη χρονιά. Η φετινή μας προσπάθεια ενδυναμώνει αυτή την πρωτοβουλία, επιβεβαιώνοντας τη σταθερή μας προσήλωση στην ανάδειξη και αξιοποίηση των νέων ανθρώπων, του πολυτιμότερου κεφαλαίου της χώρας μας. Ο φαρμακευτικός κλάδος αποτελεί έναν από τους πλέον δυναμικούς τομείς της εθνικής οικονομίας, με συνολική επίδραση στο ΑΕΠ που ξεπερνά τα 6 δισ. ευρώ και με ιδιαίτερα σημαντική συμβολή στην απασχόληση και την καινοτομία. Ο ΣΦΕΕ και οι εταιρείες-μέλη του παραμένουμε προσηλωμένοι στην υποστήριξη νέων επιστημόνων, επενδύοντας σταθερά στην ανάπτυξη και στην εκπαίδευση των μελλοντικών στελεχών μέσω προγραμμάτων δια βίου μάθησης».
Την ημερίδα τίμησαν με τη συμμετοχή τους ως ομιλητές υψηλόβαθμα στελέχη των εταιριών μελών του ΣΦΕΕ: AbbVie, AstraZeneca, Daiichi Sankyo, Demo, Lavipharm, NovoNordisk, MSD, Roche, Sanofi, Vianex, WinMedica, της εταιρείας κλινικών μελετών PPD καθώς και του Ιδρύματος Ιατροβιολογικών Ερευνών της Ακαδημίας Αθηνών.
Η εκδήλωση πραγματοποιήθηκε στο πλαίσιο του συνεδρίου «Ημέρες Παθολογίας».